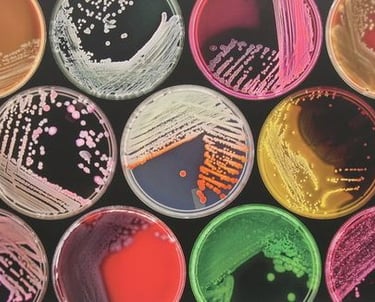

BACTERIOLOGIA
📘 Estudia las bacterias y su impacto en la salud, la industria y el ambiente.
La bacteriología es la rama de la microbiología que estudia exclusivamente a las bacterias: organismos unicelulares procariotas con una diversidad biológica asombrosa.
Analiza su estructura, metabolismo, genética, ecología y su impacto en la salud humana, el medio ambiente y la industria. Aunque algunas bacterias causan enfermedades, muchas son esenciales para procesos vitales como la digestión, la producción de alimentos y el reciclaje de nutrientes.

Aprende sobre las bacterias
🧫 Bienvenido al universo microbiano
¿Te has preguntado alguna vez qué seres viven más allá de lo que tus ojos pueden ver? En nuestra plataforma MicrobioOnline, te invitamos a descubrir el universo microscópico a través de nuestras secciones especializadas. Aquí podrás aprender, consultar y desarrollar investigaciones sobre los microorganismos que transforman nuestro cuerpo, nuestro entorno y hasta la historia de la humanidad.
Cada sección está diseñada para que estudiantes, docentes y curiosos del conocimiento encuentren contenido claro, confiable y actualizado.
🦠 ¿Qué encontrarás en Bacteriología?
Sumérgete en el estudio de las bacterias y descubre:
🔬 Estructura de la célula bacteriana: conoce cada una de sus partes y sus funciones.
🧪 Agrupaciones morfológicas: aprende a identificar las formas y agrupaciones bacterianas.
🎨 Tinción de Gram: comprende esta técnica clave para diferenciar bacterias.
🧭 Tipos de flagelos: explora cómo se mueven y adaptan estos microorganismos.
🧱 Pared celular Gram + y Gram -: compara su estructura y función.
🌟 Explora, aprende y comparte.


APRENDE CON NOSOTROS


INVESTIGA EN EL MICROSCOPIO


SE UN AMANTE DE LA MICROBIOLOGIA


DESCUBRE UN MUNDO MICROSCOPICO
Conocimiento
Difundimos ciencia en microbiología y laboratorio clínico.
Recursos
Contacto
info@microbioonline.com
© 2026 Microbioonline. Todos los derechos